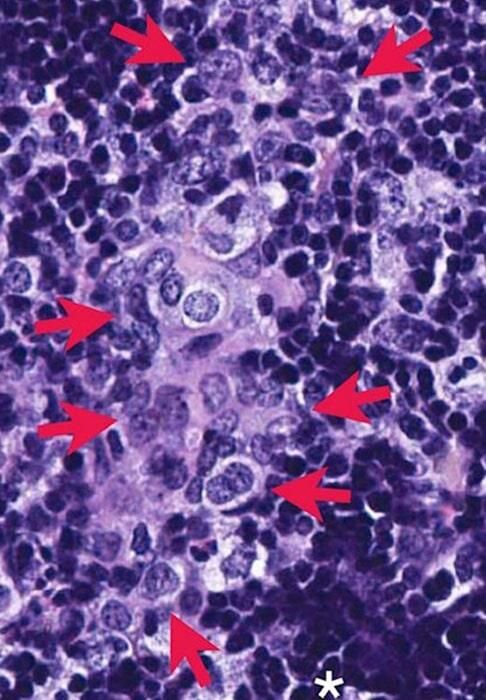

Dr. Martín Argumedo Villa
tratamientos contra cáncer en Poza Rica
El cáncer es curable si se detecta a tiempo
El
cáncer puede ser erradicado exitosamente si se detecta a tiempo, por ello es necesario hacerse pruebas periódicas para corroborar que tu salud esté en perfecto estado.
No dejes pasar más tiempo y acude a mi consultorio, para que tengas:
Siempre me enfoco en la prevención, diagnóstico, tratamiento, rehabilitación y monitorización del paciente con cáncer.
Ultrasonido
¿Para qué se usa en oncología?
El ultrasonido es un estudio de imagen que utiliza ondas sonoras para observar el interior de una parte del cuerpo. Funciona a través de un transductor que emite ondas sonoras y detecta los ecos a medida que rebotan de los tejidos del cuerpo. Es un estudio seguro, indoloro y no invasivo.
Ultrasonido de abdomen
Se utiliza para visualizar y detectar cambios en el aspecto y función de los órganos abdominales y pélvicos (páncreas, vesícula, hígado, riñones, bazo, vejiga y aorta abdominal), también detecta masas anormales, tumores y alteraciones vasculares.
Ultrasonido de abdomen
Se utiliza para visualizar y detectar cambios en el aspecto y función de los órganos abdominales y pélvicos (páncreas, vesícula, hígado, riñones, bazo, vejiga y aorta abdominal), también detecta masas anormales, tumores y alteraciones vasculares.
Ultrasonido transvaginal
Es un estudio indoloro que sirve para examinar los genitales femeninos internos, útero, ovario, cérvix, endometrio. Sirve para distinguir causas benignas y malignas de sangrado transvaginal anormal. Detectar presencia de características anormales en el endometrio, siendo uno de los métodos de diagnóstico oportuno en las pacientes con alto riesgo de cáncer de endometrio. En caso de detectarse la existencia de una lesión maligna, sirve para determinar la extensión de la enfermedad, su estado y para decidir el tipo de tratamiento a seguir.
Mastografía digitalizada
Es un estudio de imagen radiográfica de la glándula mamaria que permite detectar lesiones no palpables y diagnosticar oportunamente si alguna de ellas es maligna. Tiene la capacidad de detectar lesiones menores a un centímetro cuando todavía no es posible percibirlas por palpación. Actualmente es el mejor método de detección para el cáncer de mama ya que puede detectar lesiones en etapa temprana, cuando tienen mayor posibilidad de curación y generalmente responden a un tratamiento menos agresivo.
Martín Argumedo Villa
Médico Cirujano
Cédula Prof.: 2296751
Universidad Anáhuac
Especialidad en Cirugía Oncológica (Adultos)
Cédula Prof.: 4743021
Universidad Nacional Autónoma de México